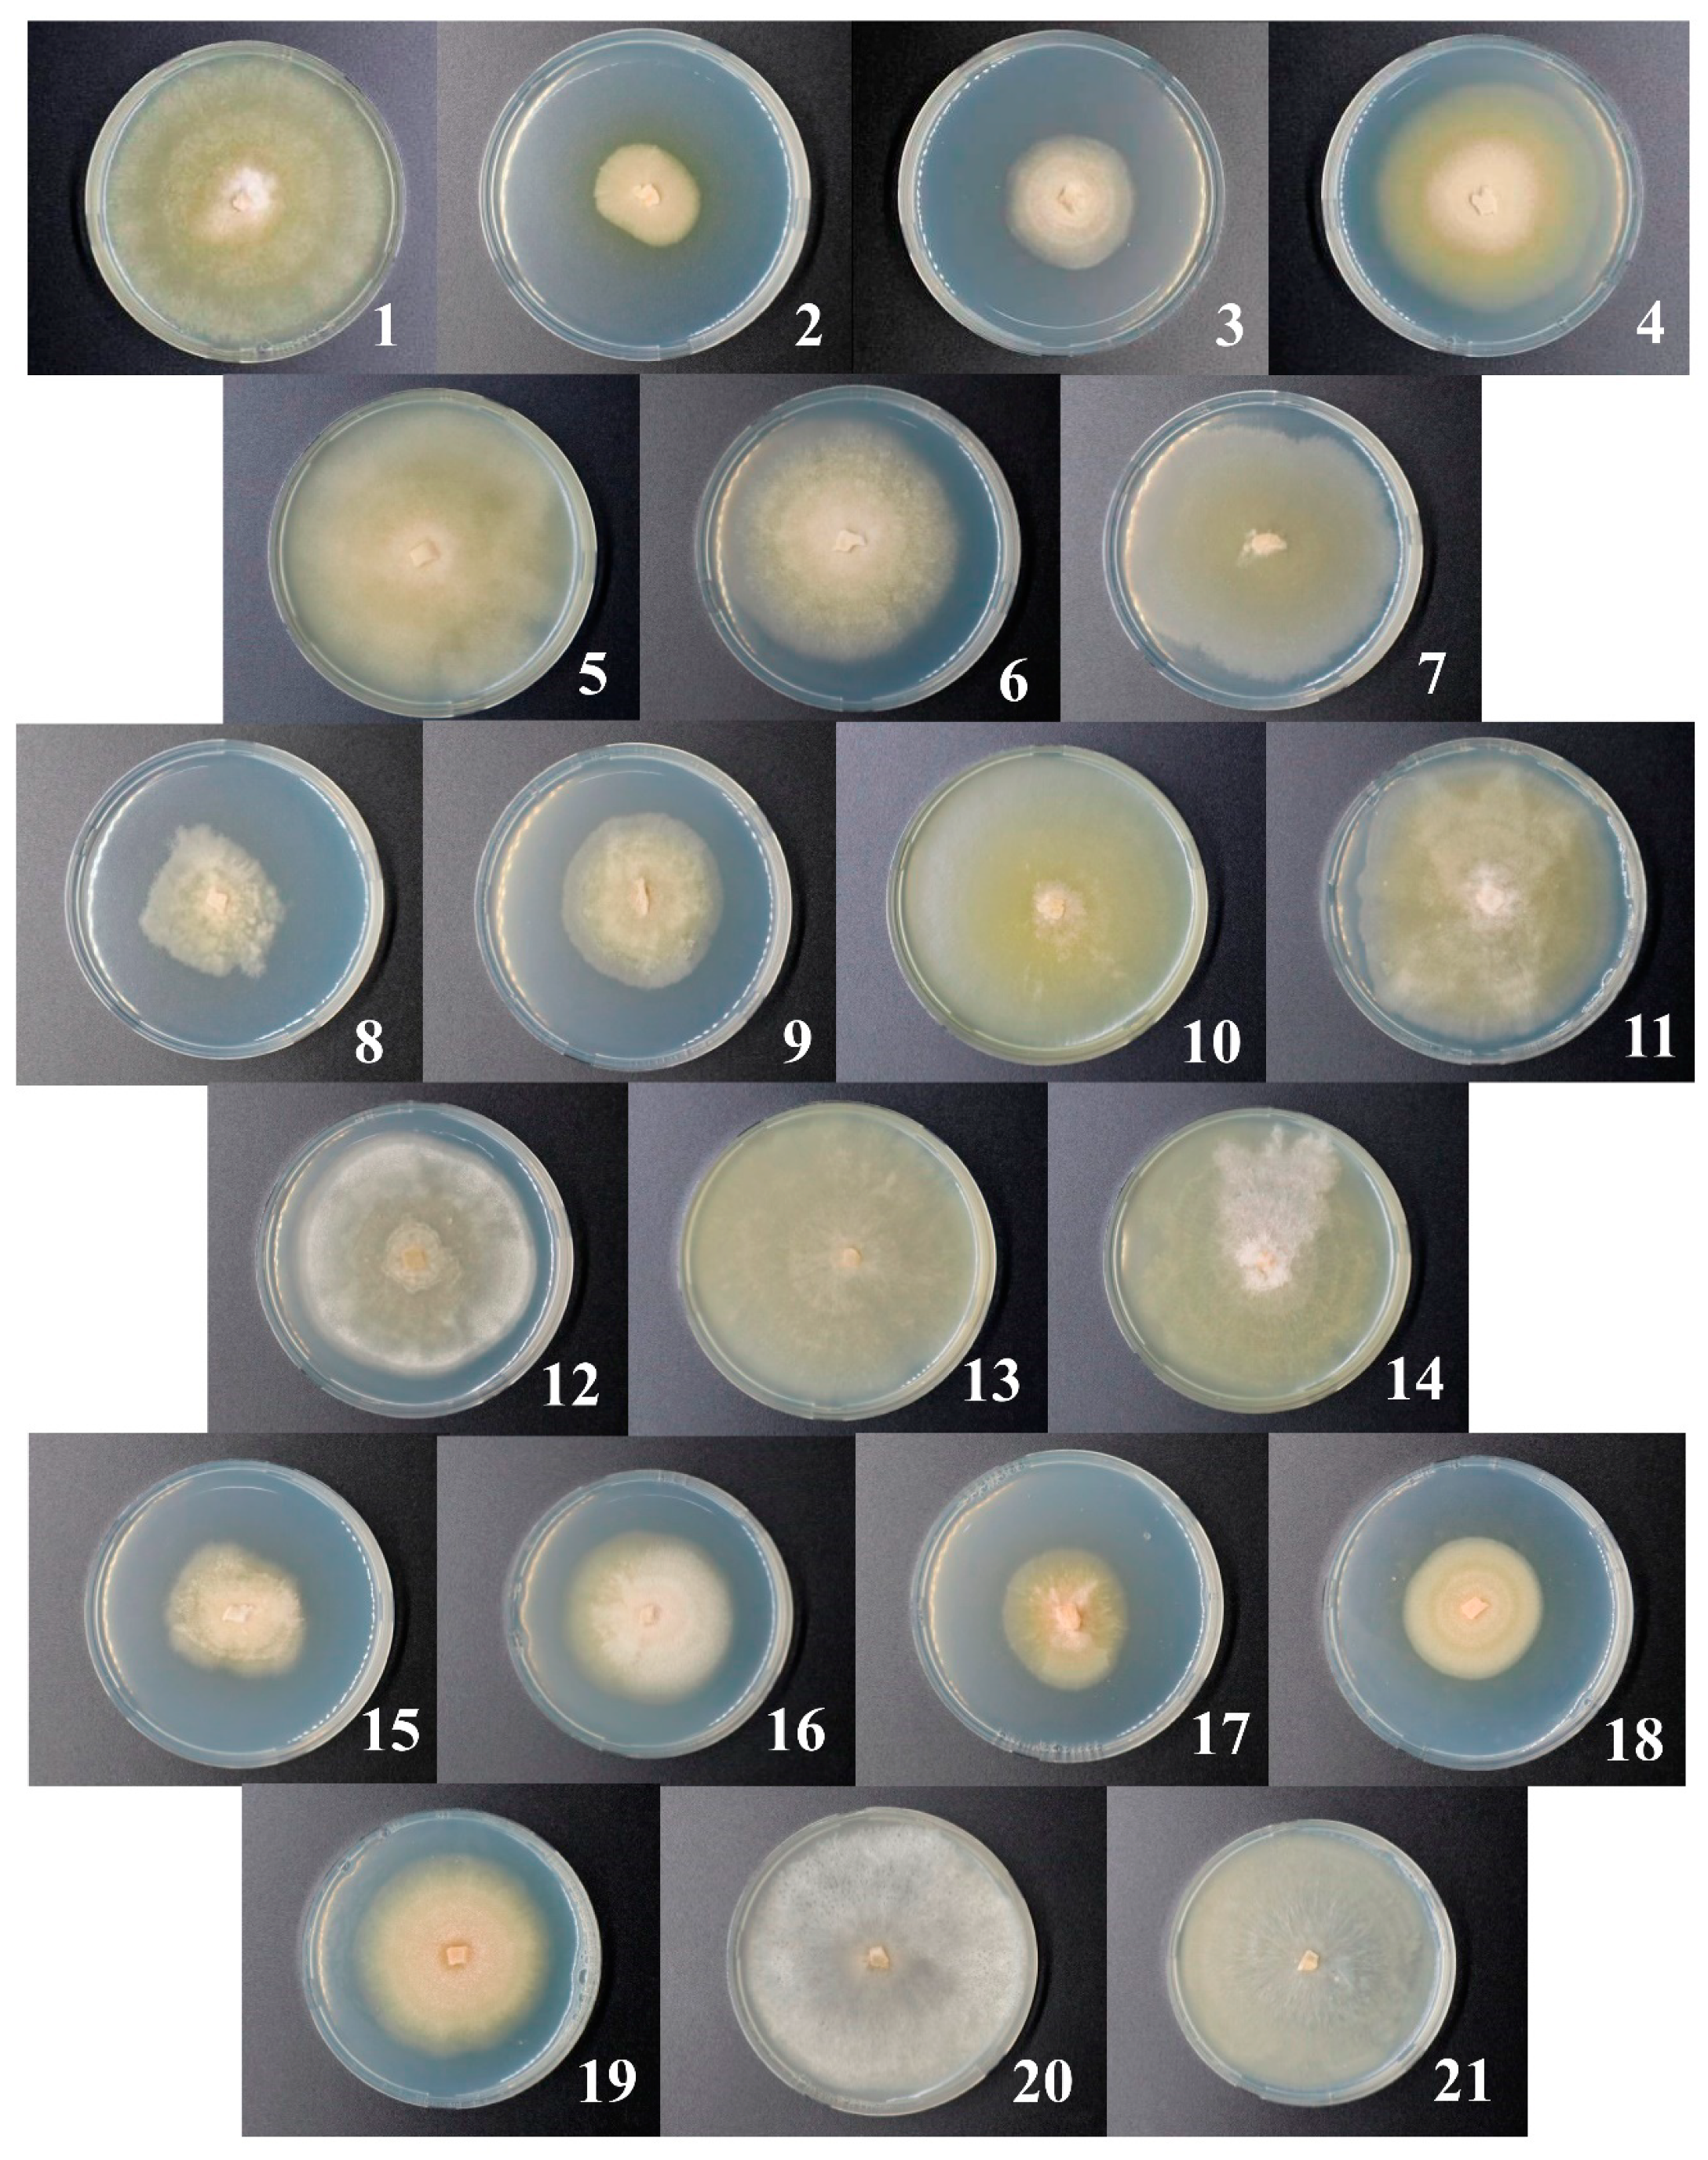
Jof 06 00335 g006 Jof 06 00335 g006

Rye Snow Mold-Associated Microdochium nivale Strains Inhabiting a Common Area: Variability in Genetics, Morphotype, Extracellular Enzymatic Activities, and Virulence
Abstract
1. Introduction
2. Materials and Methods
2.1. Sample Collection
2.2. Isolation of Microdochium sp. Strains, Analysis of Morphology, and Growth Rate
2.3. DNA Extraction, DNA Library Preparation, and Sequencing
2.4. Bioinformatic Procedures
2.5. Phylogenetic Classification of Microdochium sp. Isolates
2.6. Enzymatic Activity Assays
2.7. Virulence Assay
3. Results
3.1. Analysis of the Taxonomic Composition of the Microbiome of Snow Mold-Affected Rye Plants
3.2. Isolation of Microdochium Strains and Their Primary Characteristics
3.3. ITS Sequencing and Phylogenetic Classification of Microdochium sp. Strains
3.4. Extracellular Enzyme Activities of the Isolated M. nivale Strains
3.5. Virulence of the Isolated M. nivale Strains
4. Discussion
4.1. Microbiome of Snow Mold-Affected Rye
4.2. Microdochium nivale Strains Associated with Rye Snow Mold: Morphology, Genetics, and Enzymatic Activities
4.3. Virulence of Microdochium nivale Strains
5. Conclusions
Supplementary Materials
Author Contributions
Funding
Acknowledgments
Conflicts of Interest
References
- Bruehl, G.W. Developing Wheats Resistant to Snow Mold in Washington State. Plant Dis. 1982, 66, 1090–1095. [Google Scholar] [CrossRef]
- Hoshino, T.; Xiao, N.; Tkachenko, O.B. Cold adaptation in the phytopathogenic fungi causing snow molds. Mycoscience 2009, 50, 26–38. [Google Scholar] [CrossRef]
- Hsiang, T.; Wu, C.; Cook, S. Residual efficacy of Typhula phacorrhiza as a biocontrol agent of grey snow mold on creeping bentgrass. Can. J. Plant Pathol. 1999, 21, 382–387. [Google Scholar] [CrossRef]
- Chang, S.W.; Scheef, E.; Abler, R.A.B.; Thomson, S.; Johnson, P.; Jung, G. Distribution of Typhula spp. and Typhula ishikariensis Varieties in Wisconsin, Utah, Michigan, and Minnesota. Phytopathol. 2006, 96, 926–933. [Google Scholar] [CrossRef]
- Murray, T.D.; Jones, S.; Adams, E. Snow Mold Diseases of Winter Wheat in Washington; Washington State University: Pullman, WA, USA, 1999; pp. 1–8. Available online: http://smallgrains.wsu.edu/wp-content/uploads/2013/12/EB1880_Snowmold.pdf (accessed on 10 November 2020).
- Matsumoto, N. Snow Molds: A Group of Fungi that Prevail under Snow. Microbes Environ. 2009, 24, 14–20. [Google Scholar] [CrossRef]
- Gaudet, D.A.; Laroche, A.; Yoshida, M. Low temperature-wheat-fungal interactions: A carbohydrate connection. Physiol. Plant. 1999, 106, 437–444. [Google Scholar] [CrossRef]
- Bankina, B.; Ruza, A.; Katamadze, M.; Kreita, D.; Paura, L. Snow Mould Development under Conditions of Central Part of Latvia. Proc. Latv. Univ. Agric. 2012, 27, 1–5. [Google Scholar] [CrossRef]
- Tkachenko, O.B. Snow Mold (History of The Study, Agents, Biological Characteristics); RAS: Moscow, Russia, 2017; p. 72. [Google Scholar]
- Glinushkin, A.P.; Ovsyankina, A.V.; Kiseleva, M.I.; Kolomiets, T.M. Distribution of Fungi from the Genus Fusarium Link. on Cereals. Russ. Agric. Sci. 2018, 44, 235–240. [Google Scholar] [CrossRef]
- Ponomareva, M.L.; Ponomarev, S.N.; Mannapova, G.S.; Ilalova, L.V. Phytosanitary monitoring of the most harmful winter rye diseases in the Tatarstan Republic. Vestn. KrasGAU 2019, 9, 27–34. [Google Scholar]
- Ponomareva, M.L.; Gorshkov, V.Y.; Ponomarev, S.N.; Korzun, V.; Miedaner, T. Snow mold of winter cereals: A complex disease and a challenge for resistance breeding. Theor. Appl. Genet. 2020, 1–15. [Google Scholar] [CrossRef]
- Sheshegova, T.K. Analysis of the phytosanitary condition of spring grain crops in the Kirov region (analytical review). Agric. Sci. Euro-North-East 2015, 5, 10–14. [Google Scholar] [CrossRef]
- Utkina, E.I.; Kedrova, L.I.; Parfyenova, E.S.; Shamova, M.G. Influence of snow mold on winter rye productivity in the Kirov region. Agric. Sci. Euro-North-East 2019, 20, 315–323. [Google Scholar] [CrossRef]
- Govorov, D.N.; Zhivykh, A.V.; Novoselov, E.S.; Shabelnikova, A.A.; Nikulin, A.N.; Umnikov, V.I.; Dolgov, A.I.; Volkov, I.A. Mashentsev Review of Phytosanitary State of Agricultural Crops in the Russian Federation in 2019 and Forecast of Harmful Objects in 2020; RDA, Plant Protection and Quarantine: Moscow, Russia, 2020; p. 897. [Google Scholar]
- Smiley, R.W.; Dernoeden, P.H.; Clarke, B.B. Compendium of Turfgrass Diseases, 3rd ed.; APS Press—The American Phytopathological Society: St. Paul, MN, USA, 2005; p. 109. [Google Scholar]
- Gerlach, W.; Nirenberg, H.; Eckart, I.; Rummland, I.; Schwarz, R. The Genus Fusarium—A Pictorial Atlas. In Mitteilungen aus der Biologischen Bundesanstalt fur Land- und Forstwirtschaft Berlin-Dahlem; Kommissionsverlag Paul Parey, German Federal Republic: Berlin/Hamburg, Germany, 1982; Volume 209, pp. 1–406. [Google Scholar]
- Glynn, N.C.; Hare, M.C.; Parry, D.W.; Edwards, S.G. Phylogenetic analysis of EF-1 alpha gene sequences from isolates of Microdochium nivale leads to elevation of varieties majus and nivale to species status. Mycol. Res. 2005, 109, 872–880. [Google Scholar] [CrossRef] [PubMed]
- Matsumoto, N.; Hsiang, T. Snow Mold: The battle under Snow between Fungal Pathogens and Their Plant Hosts, 1st ed.; Springer: Singapore, 2016; p. 136. [Google Scholar]
- Istokovics, A.; Morita, N.; Izumi, K.; Hoshino, T.; Yumoto, I.; Sawada, M.T.; Ishizaki, K.; Okuyama, H. Neutral lipids, phospholipids, and a betaine lipid of the snow mold fungus Microdochium nivale. Can. J. Microbiol. 1998, 44, 1051–1059. [Google Scholar] [CrossRef]
- Hsiang, T. All you ever wanted to know about Fusarium patch/Microdochium patch/pink snow mold or whatever that disease is called. Green Master 2009, 44, 13–16. [Google Scholar]
- Humphreys, J.; Cooke, B.M.; Storey, T. Effects of seed borne Microdochium nivale on establishment and grain yield of winter-sown wheat. Plant Var. Seeds 1995, 8, 107–117. [Google Scholar]
- Parry, D.W.; Rezanoor, H.N.; Pettitt, T.R.; Hare, M.C.; Nicholson, P. Analysis of Microdochium nivale isolates from wheat in the UK during 1993. Ann. Appl. Biol. 1995, 126, 449–455. [Google Scholar] [CrossRef]
- Hudec, K.; Muchová, D. Influence of temperature and species origin on Fusarium spp. and Microdochium nivale pathogenicity to wheat seedlings. Plant Prot. Sci. 2010, 46, 59–65. [Google Scholar] [CrossRef]
- Abdelhalim, M.; Brurberg, M.B.; Hofgaard, I.S.; Rognli, O.A.; Tronsmo, A.M. Pathogenicity, host specificity and genetic diversity in Norwegian isolates of Microdochium nivale and Microdochium majus. Europ. J. Plant Pathol. 2020, 156, 1–11. [Google Scholar] [CrossRef]
- Clement, J.; Parry, D. Stem-base disease and fungal colonisation of winter wheat grown in compost inoculated with Fusarium culmorum, F. graminearum and Microdochium nivale. Eur. J. Plant Pathol. 1998, 104, 323–330. [Google Scholar] [CrossRef]
- Tronsmo, A.M.; Hsiang, T.; Okuyama, H.; Nakajima, T.A. Low temperature diseases caused by Microdochium nivale. In Low Temperature Plant Microbe Interactions under Snow; Iriki, N., Gaudet, D.A., Tronsmo, A.M., Matsumoto, N., Yoshidaand, M., Nishimune, A., Eds.; Hokkaido National Agricultural Experiment Station: Hokkaido, Japan, 2001; pp. 75–86. [Google Scholar]
- Amein, T.; Omer, Z.; Welch, C. Application and evaluation of Pseudomonas strains for biocontrol of wheat seedling blight. Crop. Prot. 2008, 27, 532–536. [Google Scholar] [CrossRef]
- Xu, X.-M.; Monger, W.; Ritieni, A.; Nicholson, P. Effect of temperature and duration of wetness during initial infection periods on disease development, fungal biomass and mycotoxin concentrations on wheat inoculated with single, or combinations of, Fusarium species. Plant Pathol. 2007, 56, 943–956. [Google Scholar] [CrossRef]
- Gorkovenko, V.S.; Oberyuhtina, L.A.; Kurkina, E.A. The harmfulness of the Microdochium nivale in agrocenosis of winter wheat. Prot. Quar. Plants 2009, 1, 34–35. (In Russian) [Google Scholar]
- Walker, A.-S.; Auclair, C.; Gredt, M.; Leroux, P. First occurrence of resistance to strobilurin fungicides in Microdochium nivale and Microdochium majus from French naturally infected wheat grains. Pest Manag. Sci. 2009, 65, 906–915. [Google Scholar] [CrossRef]
- Nielsen, L.K.; Jensen, J.D.; Nielsen, G.C.; Spliid, N.H.; Thomsen, I.K.; Justesen, A.F.; Collinge, D.B.; Jørgensen, L.N. Fusarium Head Blight of Cereals in Denmark: Species Complex and Related Mycotoxins. Phytopathology 2011, 101, 960–969. [Google Scholar] [CrossRef]
- Jorgensen, L.N.; Nielsen, L.K.; Nielsen, B.J. Control of seedling blight in winter wheat by seed treatments—Impact on emergence, crop stand, yield and deoxynivalenol. Acta Agric. Scand. Sect. B Plant Soil Sci. 2011, 62, 1–10. [Google Scholar] [CrossRef]
- Gagkaeva, T.Y.; Gavrilova, O.P.; Orina, A.S. The good news is that Microdochium fungi do not produce mycotoxins! Prot. Quar. Plants 2017, 5, 9–13. (In Russian) [Google Scholar]
- Gagkaeva, T.Y.; Gavrilova, O.P.; Orina, A.S.; Lebedin, Y.; Shanin, I.; Petukhov, P.; Eremin, S.A. Analysis of Toxigenic Fusarium Species Associated with Wheat Grain from Three Regions of Russia: Volga, Ural, and West Siberia. Toxins 2019, 11, 252. [Google Scholar] [CrossRef]
- Edwards, S.G. Influence of agricultural practices on fusarium infection of cereals and subsequent contamination of grain by trichothecene mycotoxins. Toxicol. Lett. 2004, 153, 29–35. [Google Scholar] [CrossRef]
- Kabak, B.; Dobson, A.D.W.; Var, I. Strategies to Prevent Mycotoxin Contamination of Food and Animal Feed: A Review. Crit. Rev. Food Sci. Nutr. 2006, 46, 593–619. [Google Scholar] [CrossRef]
- O’Donnell, K.; Ward, T.J.; Robert, V.; Crous, P.; Geiser, D.M.; Kang, S. DNA sequence-based identification of Fusarium: Current status and future directions. Phytoparasitica 2015, 43, 583–595. [Google Scholar] [CrossRef]
- Ren, R.; Yang, X.; Ray, R. Comparative aggressiveness of Microdochium nivale and M. majus and evaluation of screening methods for Fusarium seedling blight resistance in wheat cultivars. Eur. J. Plant Pathol. 2014, 141, 281–294. [Google Scholar] [CrossRef]
- Gagkaeva, T.; Orina, A.S.; Gavrilova, O.P.; Gogina, N.N. Evidence of Microdochium Fungi Associated with Cereal Grains in Russia. Microorganisms 2020, 8, 340. [Google Scholar] [CrossRef] [PubMed]
- Gavrilova, O.P.; Orina, A.S.; Kessenikh, E.D.; Gustyleva, L.K.; Savelieva, E.I.; Gogina, N.N.; Gagkaeva, T.Y. Diversity of Physiological and Biochemical Characters of Microdochium Fungi. Chem. Biodivers. 2020, 17, 2000294. [Google Scholar] [CrossRef] [PubMed]
- Dubas, E.; Golebiowska, G.; Żur, I.; Wędzony, M. Microdochium nivale (Fr., Samuels & Hallett): Cytological analysis of the infection process in triticale (×Triticosecale Wittm.). Acta Physiol. Plant. 2010, 33, 529–537. [Google Scholar] [CrossRef][Green Version]
- Żur, I.; Dubas, E.; Pociecha, E.; Dubert, F.; Kolasińska, I.; Płażek, A. Cytological analysis of infection process and the first defence responses induced in winter rye (Secale cereale L.) seedlings inoculated with Microdochium nivale. Physiol. Mol. Plant Pathol. 2011, 76, 189–196. [Google Scholar] [CrossRef]
- Hofgaard, I.S.; Wanner, L.A.; Hageskal, G.; Henriksen, B.; Klemsdal, S.S.; Tronsmo, A.M. Isolates of Microdochium nivale and M. majus Differentiated by Pathogenicity on Perennial Ryegrass (Lolium perenne L.) and in vitro Growth at Low Temperature. J. Phytopathol. 2006, 154, 267–274. [Google Scholar] [CrossRef]
- Jewell, L.E.; Hsiang, T. Multigene differences between Microdochium nivale and Microdochium majus. Botany 2013, 91, 99–106. [Google Scholar] [CrossRef]
- Hayashi, Y.; Kozawa, T.; Aiuchi, D.; Koike, M.; Akino, S.; Kondo, N. Population genetic structure of Microdochium majus and Microdochium nivale associated with Fusarium head blight of wheat in Hokkaido, Japan. Eur. J. Plant Pathol. 2014, 140, 787–795. [Google Scholar] [CrossRef]
- Ioos, R.; Belhadj, A.; Menez, M. Occurrence and distribution of Microdochium nivale and Fusarium species isolated from barley, durum and soft wheat grains in France from 2000 to 2002. Mycopathologia 2004, 158, 351–362. [Google Scholar] [CrossRef]
- Maurin, N.; Saur, L.; Capron, G. Stem and head reaction of winter wheat cultivars to artificial inoculation by Microdochium nivale under controlled environment and field conditions. Euphytica 1995, 92, 359–366. [Google Scholar] [CrossRef]
- Simpson, D.; Rezanoor, H.; Parry, D.; Nicholson, P. Evidence for differential host preference in Microdochium nivale var. majus and Microdochium nivale var. nivale. Plant Pathol. 2000, 49, 261–268. [Google Scholar] [CrossRef]
- Smith, J.D. Fusarium nivale (Gerlachia nivalis) from cereals and grasses: Is it the same fungus? Can. Plant Dis. Surv. 1983, 63, 25–26. [Google Scholar]
- Lees, A.; Nicholson, P.; Rezanoor, H.; Parry, D. Analysis of variation within Microdochium nivale from wheat: Evidence for a distinct sub-group. Mycol. Res. 1995, 99, 103–109. [Google Scholar] [CrossRef]
- Diamond, H.; Cooke, B.M. Host Specialisation in Microdochium nivale on Cereals. Cereal Res. Commun. 1997, 25, 533–538. [Google Scholar] [CrossRef]
- Mahuku, G.; Hsiang, T.; Yang, L. Genetic diversity of Microdochium nivale isolates from turfgrass. Mycol. Res. 1998, 102, 559–567. [Google Scholar] [CrossRef][Green Version]
- Płażek, A.; Dubert, F.; Pociecha, E.; Janowiak, F.; Kolasińska, I.; Maciejewski, M. Resistance of Winter Rye (Secale cereale L.) to Microdochium nivale Depends on Soluble Carbohydrate Content but not on Abscisic Acid Level. J. Phytopathol. 2011, 159, 751–758. [Google Scholar] [CrossRef]
- Pociecha, E.; Janowiak, F.; Dubas, E.; Żur, I.; Tokarz, K.; Kolasińska, I.; Płażek, A. Progress of snow mould infection in crowns of winter rye (Secale cereale L.) is related to photosynthetic activity during cold acclimation. Plant Physiol. Biochem. 2013, 70, 360–367. [Google Scholar] [CrossRef]
- Nielsen, L.; Justesen, A.F.; Jensen, J.; Jorgensen, L.N. Microdochium nivale and Microdochium majus in seed samples of Danish small grain cereals. Crop. Prot. 2013, 43, 192–200. [Google Scholar] [CrossRef]
- Prończuk, M.; Madej, L.J. Evaluation of Microdochium nivale infection on rye genotypes using different methods. Vortr. Pflanzenzuecht. 1996, 35, 190–192. [Google Scholar]
- Booth, C. Chapter II Fungal Culture Media. In Methods in Microbiology; Booth, C., Ed.; Academic Press: London, UK, 1971; Volume 4, pp. 49–94. [Google Scholar]
- Toju, H.; Tanabe, A.S.; Yamamoto, S.; Sato, H. High-Coverage ITS Primers for the DNA-Based Identification of Ascomycetes and Basidiomycetes in Environmental Samples. PLoS ONE 2012, 7, e40863. [Google Scholar] [CrossRef] [PubMed]
- Herlemann, D.P.R.; Labrenz, M.; Jürgens, K.; Bertilsson, S.; Waniek, J.J.; Andersson, A.F. Transitions in bacterial communities along the 2000 km salinity gradient of the Baltic Sea. ISME J. 2011, 5, 1571–1579. [Google Scholar] [CrossRef] [PubMed]
- Martin, M. Cutadapt removes adapter sequences from high-throughput sequencing reads. EMBnet J. 2011, 17, 10–12. [Google Scholar] [CrossRef]
- Callahan, B.J.; McMurdie, P.J.; Rosen, M.J.; Han, A.W.; Johnson, A.J.A.; Holmes, S.P. DADA2: High-resolution sample inference from Illumina amplicon data. Nat. Methods 2016, 13, 581–583. [Google Scholar] [CrossRef]
- Abarenkov, K.; Zirk, A.; Piirmann, T.; Pöhönen, R.; Ivanov, F.; Nilsson, R.H.; Kõljalg, U. UNITE general FASTA release for Fungi 2. Version 04.02.2020. UNITE Community 2020. [Google Scholar] [CrossRef]
- Mahé, F.; Rognes, T.; Quince, C.; De Vargas, C.; Dunthorn, M. Swarm v2: Highly-scalable and high-resolution amplicon clustering. PeerJ 2015, 3, e1420. [Google Scholar] [CrossRef]
- Bengtsson-Palme, J.; Ryberg, M.; Hartmann, M.; Branco, S.; Wang, Z.; Godhe, A.; De Wit, P.; Sánchez-García, M.; Ebersberger, I.; de Sousa, F.; et al. Improved software detection and extraction of ITS1 and ITS2 from ribosomal ITS sequences of fungi and other eukaryotes for analysis of environmental sequencing data. Methods Ecol. Evol. 2013, 4, 914–919. [Google Scholar] [CrossRef]
- Dhariwal, A.; Chong, J.; Habib, S.; King, I.L.; Agellon, L.B.; Xia, J. MicrobiomeAnalyst: A web-based tool for comprehensive statistical, visual and meta-analysis of microbiome data. Nucleic Acids Res. 2017, 45, W180–W188. [Google Scholar] [CrossRef]
- Crooks, G.E.; Hon, G.; Chandonia, J.-M.; Brenner, S.E. WebLogo: A Sequence Logo Generator. Genome Res. 2004, 14, 1188–1190. [Google Scholar] [CrossRef]
- Ronquist, F.; Teslenko, M.; Van Der Mark, P.; Ayres, D.L.; Darling, A.; Höhna, S.; Larget, B.; Liu, L.; Suchard, M.A.; Huelsenbeck, J.P. MrBayes 3.2: Efficient Bayesian Phylogenetic Inference and Model Choice Across a Large Model Space. Syst. Biol. 2012, 61, 539–542. [Google Scholar] [CrossRef]
- Kumar, S.; Stecher, G.; Li, M.; Knyaz, C.; Tamura, K. MEGA X: Molecular Evolutionary Genetics Analysis across Computing Platforms. Mol. Biol. Evol. 2018, 35, 1547–1549. [Google Scholar] [CrossRef] [PubMed]
- Miller, G.L. Use of Dinitrosalicylic Acid Reagent for Determination of Reducing Sugar. Anal. Chem. 1959, 31, 426–428. [Google Scholar] [CrossRef]
- Sakthi, S.S.; Kanchana, D.; Saranraj, P.; Usharani, G. Evaluation of amylase activity of the amylolytic fungi Aspergillus niger using cassava as substrate. Int. J. App. Microbiol. Sci. 2012, 1, 24–34. [Google Scholar]
- De Paula, C.C.P.; Montoya, Q.V.; Meirelles, L.A.; Farinas, C.S.; Rodrigues, A.; Seleghim, M.H. High cellulolytic activities in filamentous fungi isolated from an extreme oligotrophic subterranean environment (Catão cave) in Brazil. Anais Acad. Bras. Ciênc. 2019, 91, e20180583. [Google Scholar] [CrossRef]
- Nagar, S.; Mittal, A.; Gupta, V.K. A Cost Effective Method for Screening and Isolation of Xylan Degrading Bacteria Using Agro Waste Material. Asian J. Biol. Sci. 2012, 5, 384–394. [Google Scholar] [CrossRef][Green Version]
- Cairns, A.J.; Howarth, C.J.; Pollock, C.J. Submerged batch culture of the psychrophile Monographella nivalis in a defined medium; growth, carbohydrate utilization and responses to temperature. New Phytol. 1995, 129, 299–308. [Google Scholar] [CrossRef]
- Cupp-Enyard, C. Sigma’s Non-specific Protease Activity Assay—Casein as a Substrate. J. Vis. Exp. 2008, 19, e899. [Google Scholar] [CrossRef]
- Kozlova, L.; Mikshina, P.V.; Gorshkova, T.A. Assay of Arabinofuranosidase Activity in Maize Roots. Bio Protoc. 2016, 6, 6. [Google Scholar] [CrossRef]
- Shevchik, V.E.; Robert-Baudouy, J.; Hugouvieux-Cotte-Pattat, N. Pectate lyase PelI of Erwinia chrysanthemi 3937 belongs to a new family. J. Bacteriol. 1997, 179, 7321–7330. [Google Scholar] [CrossRef]
- Orth, A.B.; Royse, D.J.; Tien, M. Ubiquity of lignin-degrading peroxidases among various wood-degrading fungi. Appl. Environ. Microbiol. 1993, 59, 4017–4023. [Google Scholar] [CrossRef]
- Bradford, M.M. A rapid and sensitive method for the quantitation of microgram quantities of protein utilizing the principle of protein–dye binding. Anal. Biochem. 1976, 72, 248–254. [Google Scholar] [CrossRef]
- Chao, A. Nonparametric estimation of the number of classes in a population. Scand. J. Stat. 1984, 11, 265–270. [Google Scholar]
- Colwell, R.K.; Coddington, J.A. Estimating terrestrial biodiversity through extrapolation. Philos. Trans. R. Soc. B Biol. Sci. 1994, 345, 101–118. [Google Scholar] [CrossRef]
- Schmidt, J.E.; Kent, A.D.; Brisson, V.L.; Gaudin, A.C.M. Agricultural management and plant selection interactively affect rhizosphere microbial community structure and nitrogen cycling. Microbiome 2019, 7, 1–18. [Google Scholar] [CrossRef]
- Vieira, S.; Sikorski, J.; Dietz, S.; Herz, K.; Schrumpf, M.; Bruelheide, H.; Scheel, D.; Friedrich, M.W.; Overmann, J. Drivers of the composition of active rhizosphere bacterial communities in temperate grasslands. ISME J. 2020, 14, 463–475. [Google Scholar] [CrossRef]
- Hernández-Restrepo, M.; Groenewald, J.Z.; Crous, P.W. Taxonomic and phylogenetic re-evaluation of Microdochium, Monographella and Idriella. Persoonia 2016, 36, 57–82. [Google Scholar] [CrossRef]
- Marin-Felix, Y.; Hernández-Restrepo, M.; Wingfield, M.; Akulov, A.; Carnegie, A.; Cheewangkoon, R.; Gramaje, D.; Groenewald, J.; Guarnaccia, V.; Halleen, F.; et al. Genera of phytopathogenic fungi: GOPHY 2. Stud. Mycol. 2019, 92, 47–133. [Google Scholar] [CrossRef]
- Liang, J.; Li, G.; Zhao, M.; Cai, L. A new leaf blight disease of turfgrasses caused by Microdochium poae, sp. nov. Mycologia 2019, 111, 265–273. [Google Scholar] [CrossRef]
- Das, K.; Lee, S.-Y.; Jung, H.-Y. Molecular and Morphological Characterization of Two Novel Species Collected from Soil in Korea. Mycobiology 2019, 48, 9–19. [Google Scholar] [CrossRef]
- Manirajan, B.A.; Ratering, S.; Rusch, V.; Schwiertz, A.; Geissler-Plaum, R.; Cardinale, M.; Schnell, S. Bacterial microbiota associated with flower pollen is influenced by pollination type, and shows a high degree of diversity and species-specificity. Environ. Microbiol. 2016, 18, 5161–5174. [Google Scholar] [CrossRef]
- Voříšková, J.; Baldrian, P. Fungal community on decomposing leaf litter undergoes rapid successional changes. ISME J. 2012, 7, 477–486. [Google Scholar] [CrossRef] [PubMed]
- Tláskal, V.; Voříšková, J.; Baldrian, P. Bacterial succession on decomposing leaf litter exhibits a specific occurrence pattern of cellulolytic taxa and potential decomposers of fungal mycelia. FEMS Microbiol. Ecol. 2016, 92, fiw177. [Google Scholar] [CrossRef] [PubMed]
- Durán, P.; Barra, P.J.; Jorquera, M.A.; Viscardi, S.; Fernandez, C.; Paz, C.; Mora, M.D.L.L.; Bol, R. Occurrence of Soil Fungi in Antarctic Pristine Environments. Front. Bioeng. Biotechnol. 2019, 7, 28. [Google Scholar] [CrossRef] [PubMed]
- Hirooka, Y.; Rossman, A.; Samuels, G.; Lechat, C.; Chaverri, P. A monograph of Allantonectria, Nectria, and Pleonectria (Nectriaceae, Hypocreales, Ascomycota) and their pycnidial, sporodochial, and synnematous anamorphs. Stud. Mycol. 2012, 71, 1–210. [Google Scholar] [CrossRef] [PubMed]
- Koizumi, T.; Nara, K. Communities of Putative Ericoid Mycorrhizal Fungi Isolated from Alpine Dwarf Shrubs in Japan: Effects of Host Identity and Microhabitat. Microbes Environ. 2017, 32, 147–153. [Google Scholar] [CrossRef] [PubMed]
- Quijada, L.; Huhtinen, S.; Beltrán-Tejera, E. Studies in Hyaloscyphaceae associated with major vegetation types in the Canary Islands I: Cistellaand Hyphodiscus. Willdenowia 2015, 45, 131–146. [Google Scholar] [CrossRef]
- Margesin, R.; Fonteyne, P.-A.; Schinner, F.; Sampaio, J.P. Rhodotorula psychrophila sp. nov., Rhodotorula psychrophenolica sp. nov. and Rhodotorula glacialis sp. nov., novel psychrophilic basidiomycetous yeast species isolated from alpine environments. Int. J. Syst. Evol. Microbiol. 2007, 57, 2179–2184. [Google Scholar] [CrossRef]
- De Menezes, G.C.; Amorim, S.S.; Gonçalves, V.N.; Godinho, V.M.; Simões, J.C.; Rosa, C.A.; Rosa, L.H. Diversity, Distribution, and Ecology of Fungi in the Seasonal Snow of Antarctica. Microorganisms 2019, 7, 445. [Google Scholar] [CrossRef]
- De Menezes, G.C.A.; Porto, B.A.; Amorim, S.S.; Zani, C.L.; Alves, T.M.D.A.; Junior, P.A.S.; Murta, S.M.F.; Simões, J.C.; Cota, B.B.; Rosa, C.A.; et al. Fungi in glacial ice of Antarctica: Diversity, distribution and bioprospecting of bioactive compounds. Extremophiles 2020, 24, 367–376. [Google Scholar] [CrossRef]
- Klaubauf, S.; Inselsbacher, E.; Zechmeister-Boltenstern, S.; Wanek, W.; Gottsberger, R.; Strauss, J.; Gorfer, M. Molecular diversity of fungal communities in agricultural soils from Lower Austria. Fungal Divers. 2010, 44, 65–75. [Google Scholar] [CrossRef]
- Stukenbrock, E.H.; Banke, S.; Javan-Nikkhah, M.; McDonald, B.A. Origin and Domestication of the Fungal Wheat Pathogen Mycosphaerella graminicola via Sympatric Speciation. Mol. Biol. Evol. 2006, 24, 398–411. [Google Scholar] [CrossRef] [PubMed]
- Desjardins, A.E. Gibberella from A (Venaceae) to Z (Eae). Annu. Rev. Phytopathol. 2003, 41, 177–198. [Google Scholar] [CrossRef] [PubMed]
- Crous, P.; Groenewald, J.E.; Gams, W. Eyespot of Cereals Revisited: ITS phylogeny Reveals New Species Relationships. Eur. J. Plant Pathol. 2003, 109, 841–850. [Google Scholar] [CrossRef]
- Bolton, M.D.; Thomma, B.P.H.J.; Nelson, B.D. Sclerotinia sclerotiorum (Lib.) de Bary: Biology and molecular traits of a cosmopolitan pathogen. Mol. Plant Pathol. 2006, 7, 1–16. [Google Scholar] [CrossRef]
- Friberg, H.; Persson, P.; Jensen, D.F.; Bergkvist, G. Preceding crop and tillage system affect winter survival of wheat and the fungal communities on young wheat roots and in soil. FEMS Microbiol. Lett. 2019, 366, fnz189. [Google Scholar] [CrossRef]
- Alshannaq, A.; Yu, J.-H. Occurrence, Toxicity, and Analysis of Major Mycotoxins in Food. Int. J. Environ. Res. Public Health 2017, 14, 632. [Google Scholar] [CrossRef]
- Grudzinska-Sterno, M.; Yuen, J.; Stenlid, J.; Djurle, A. Fungal communities in organically grown winter wheat affected by plant organ and development stage. Eur. J. Plant Pathol. 2016, 146, 401–417. [Google Scholar] [CrossRef]
- Gross, A.; Holdenrieder, O.; Pautasso, M.; Queloz, V.; Sieber, T.N. Hymenoscyphus pseudoalbidus, the causal agent of European ash dieback. Mol. Plant Pathol. 2013, 15, 5–21. [Google Scholar] [CrossRef]
- Kowalski, T.; Holdenrieder, O. The teleomorph of Chalara fraxinea, the causal agent of ash dieback. For. Pathol. 2009, 39, 304–308. [Google Scholar] [CrossRef]
- Michel, V.V. First Report of Chalara elegans on Roots of Black Elderberry. Plant Dis. 2009, 93, 963. [Google Scholar] [CrossRef]
- Tahiri-Alaoui, A.; Dumas, E.; Gianinazzi, S. Detection of PR-b proteins in tobacco roots infected with Chalara elegans. Plant Mol. Biol. 1990, 14, 869–871. [Google Scholar] [CrossRef] [PubMed]
- Hambleton, S.; Nickerson, N.L.; Seifert, K.A. Leohumicola, a new genus of heat-resistant hyphomycetes. Stud. Mycol. 2005, 53, 29–52. [Google Scholar] [CrossRef]
- Nguyen, H.; Seifert, K. Description and DNA barcoding of three new species of Leohumicola from South Africa and the United States. Persoonia 2008, 21, 57–69. [Google Scholar] [CrossRef] [PubMed]
- Lechat, C.; Fournier, J. Two new species of Lasionectria (Bionectriaceae, Hypocreales) from Guadeloupe and Martinique (French West Indies). Mycotaxon 2013, 121, 275–280. [Google Scholar] [CrossRef]
- Ogaki, M.B.; Teixeira, D.R.; Vieira, R.; Lirio, J.M.; Felizardo, J.P.; Abuchacra, R.C.; Cardoso, R.P.; Zani, C.L.; Alves, T.M.; Junior, P.A.; et al. Diversity and bioprospecting of cultivable fungal assemblages in sediments of lakes in the Antarctic Peninsula. Fungal Biol. 2020, 124, 601–611. [Google Scholar] [CrossRef]
- Perini, L.; Gostinčar, C.; Gunde-Cimerman, N. Fungal and bacterial diversity of Svalbard subglacial ice. Sci. Rep. 2019, 9, 20230. [Google Scholar] [CrossRef]
- Orton, E.S.; Deller, S.; Brown, J.K. Mycosphaerella graminicola: From genomics to disease control. Mol. Plant Pathol. 2011, 12, 413–424. [Google Scholar] [CrossRef]
- Lucas, J.A.; Dyer, P.S.; Murray, T.D. Pathogenicity, hostspecificity and population biology of Tapesia yallundae spp., causal agents of eyespot disease of cereals T. acuformis and occurrence of apothecia in the U.S. Pac. Northwest Adv. Bot. Res. 2000, 33, 226–258. [Google Scholar] [CrossRef]
- Sun, H.; Feng, J.; Liang, Y.; Wang, Z.; Wang, T. Application of omics approaches in Sclerotinia sclerotiorum. Sheng Wu Gong Cheng Xue Bao 2019, 35, 589–597. [Google Scholar]
- Oses-Pedraza, R.; Torres-Díaz, C.; Lavín, P.; Retamales-Molina, P.; Atala, C.; Gallardo-Cerda, J.; Acuña-Rodríguez, I.S.; Molina-Montenegro, M.A. Root endophytic Penicillium promotes growth of Antarctic vascular plants by enhancing nitrogen mineralization. Extremophiles 2020, 24, 1–12. [Google Scholar] [CrossRef]
- Bizabani, C.; Dames, J.F. Assimilation of organic and inorganic nutrients by Erica root fungi from the fynbos ecosystem. Fungal Biol. 2016, 120, 370–375. [Google Scholar] [CrossRef] [PubMed]
- Ashrafi, S.; Knapp, D.G.; Blaudez, D.; Chalot, M.; Maciá-Vicente, J.G.; Zagyva, I.; Dababat, A.A.; Maier, W.; Kovács, G.M. Inhabiting plant roots, nematodes, and truffles—Polyphilus, a new helotialean genus with two globally distributed species. Mycologia 2018, 110, 286–299. [Google Scholar] [CrossRef] [PubMed]
- Quaedvlieg, W.; Verkley, G.; Shin, H.-D.; Barreto, R.; Alfenas, A.; Swart, W.; Groenewald, J.; Crous, P. Sizing up Septoria. Stud. Mycol. 2013, 75, 307–390. [Google Scholar] [CrossRef] [PubMed]
- Gilon, M.; Arseniuk, E. Natural field infections of wheat and triticale by fungi from the complex of fungi Stagonospora nodorum/Septoria tritici under climatic conditions of Poland. Commun. Agric. Appl. Biol. Sci. 2014, 79, 216–227. [Google Scholar] [PubMed]
- Liu, Q.; Tian, J.-H.; Liu, H.-C.; Zhou, Y.-G.; Xin, Y.-H. Cryobacterium melibiosiphilum sp. nov., a psychrophilic bacterium isolated from glacier ice. Int. J. Syst. Evol. Microbiol. 2019, 69, 3276–3280. [Google Scholar] [CrossRef]
- Gosink, J.J. Polaromonas. In Bergey’s Manual of Systematics of Archaea and Bacteria (Online Book); Trujillo, M.E., Dedysh, S., DeVos, P., Hedlund, B., Kämpfer, P., Rainey, F.A., Whitman, W.B., Eds.; Wiley: Hoboken, NJ, USA, 2015. [Google Scholar] [CrossRef]
- Gillis, M.; Logan, N.A. Janthinobacterium. In Bergey’s Manual of Systematics of Archaea and Bacteria (Online Book); Trujillo, M.E., Dedysh, S., DeVos, P., Hedlund, B., Kämpfer, P., Rainey, F.A., Whitman, W.B., Eds.; Wiley: Hoboken, NJ, USA, 2015. [Google Scholar] [CrossRef]
- Glick, B.R. The enhancement of plant growth by free-living bacteria. Can. J. Microbiol. 1995, 41, 109–117. [Google Scholar] [CrossRef]
- Haas, D.; Défago, G. Biological control of soil-borne pathogens by fluorescent pseudomonads. Nat. Rev. Genet. 2005, 3, 307–319. [Google Scholar] [CrossRef]
- Mahoney, A.K.; Yin, C.; Hulbert, S.H. Community Structure, Species Variation, and Potential Functions of Rhizosphere-Associated Bacteria of Different Winter Wheat (Triticum aestivum) Cultivars. Front. Plant Sci. 2017, 8, 132. [Google Scholar] [CrossRef]
- Yin, C.; Hulbert, S.H.; Schroeder, K.L.; Mavrodi, O.; Mavrodi, D.; Dhingra, A.; Schillinger, W.F.; Paulitz, T. Role of Bacterial Communities in the Natural Suppression of Rhizoctonia solani Bare Patch Disease of Wheat (Triticum aestivum L.). Appl. Environ. Microbiol. 2013, 79, 7428–7438. [Google Scholar] [CrossRef]
- Stes, E.; Francis, I.; Pertry, I.; Dolzblasz, A.; Depuydt, S.; Vereecke, D. The leafy gall syndrome induced by Rhodococcus fascians. FEMS Microbiol. Lett. 2013, 342, 187–195. [Google Scholar] [CrossRef]
- Di Benedetto, N.A.; Corbo, M.R.; Campaniello, D.; Cataldi, M.P.; Bevilacqua, A.; Sinigaglia, M.; Flagella, Z. The role of Plant Growth Promoting Bacteria in improving nitrogen use efficiency for sustainable crop production: A focus on wheat. AIMS Microbiol. 2017, 3, 413–434. [Google Scholar] [CrossRef] [PubMed]
- Qin, Y.; Fu, Y.; Dong, C.; Jia, N.; Liu, H. Shifts of microbial communities of wheat (Triticum aestivum L.) cultivation in a closed artificial ecosystem. Appl. Microbiol. Biotechnol. 2016, 100, 4085–4095. [Google Scholar] [CrossRef] [PubMed]
- Kuźniar, A.; Włodarczyk, K.; Grządziel, J.; Goraj, W.; Gałązka, A.; Wolińska, A. Culture-independent analysis of an endophytic core microbiome in two species of wheat: Triticum aestivum L. (cv. ‘Hondia’) and the first report of microbiota in Triticum spelta L. (cv. ‘Rokosz’). Syst. Appl. Microbiol. 2020, 43, 126025. [Google Scholar] [CrossRef] [PubMed]
- Robinson, R.J.; Fraaije, B.A.; Clark, I.M.; Jackson, R.W.; Hirsch, P.R.; Mauchline, T.H. Endophytic bacterial community composition in wheat (Triticum aestivum) is determined by plant tissue type, developmental stage and soil nutrient availability. Plant Soil 2016, 405, 381–396. [Google Scholar] [CrossRef]
- Rilling, J.I.; Acuña, J.J.; Sadowsky, M.J.; Jorquera, M.A. Putative Nitrogen-Fixing Bacteria Associated With the Rhizosphere and Root Endosphere of Wheat Plants Grown in an Andisol From Southern Chile. Front. Microbiol. 2018, 9, 2710. [Google Scholar] [CrossRef]
- Karray, F.; Gargouri, M.; Chebaane, A.; Mhiri, N.; Mliki, A.; Sayadi, S. Climatic Aridity Gradient Modulates the Diversity of the Rhizosphere and Endosphere Bacterial Microbiomes of Opuntia ficus-indica. Front. Microbiol. 2020, 11, 1622. [Google Scholar] [CrossRef]
- Kaewkla, O.; Franco, C.M.M. Promicromonospora callitridis sp. nov., an endophytic actinobacterium isolated from the surface-sterilized root of an Australian native pine tree. Int. J. Syst. Evol. Microbiol. 2017, 67, 3559–3563. [Google Scholar] [CrossRef]
- Staley, J.T.; Irgens, R.L.; Brenner, D.J.; Pichinoty, F.; De Barjac, H.; Mandel, M.; Asselineau, J. Enhydrobacter aerosaccus gen. nov., sp. nov., a Gas-Vacuolated, Facultatively Anaerobic, Heterotrophic Rod. Int. J. Syst. Bacteriol. 1987, 37, 289–291. [Google Scholar] [CrossRef]
- Miura, T.; Sánchez, R.; Castañeda, L.E.; Godoy, K.; Barbosa, O. Shared and unique features of bacterial communities in native forest and vineyard phyllosphere. Ecol. Evol. 2019, 9, 3295–3305. [Google Scholar] [CrossRef]
- Marupakula, S.; Mahmood, S.; Finlay, R. Analysis of single root tip microbiomes suggests that distinctive bacterial communities are selected by Pinus sylvestris roots colonized by different ectomycorrhizal fungi. Environ. Microbiol. 2015, 18, 1470–1483. [Google Scholar] [CrossRef]
- Rothen, C.P.; Miranda, M.V.; Fracchia, S.; Godeas, A.M.; Rodriguez, M.A. Microdochium bolleyi (Ascomycota: Xylariales): Physiological characterization and structural features of its association with wheat. Bol. Soc. Argent. Bot. 2018, 53, 169–182. [Google Scholar] [CrossRef]
- Ramos, A.M.; Gally, M.; Szapiro, G.; Itzcovich, T.; Carabajal, M.; Levin, L. In vitro growth and cell wall degrading enzyme production by Argentinean isolates of Macrophomina phaseolina, the causative agent of charcoal rot in corn. Rev. Argent. Microbiol. 2016, 48, 267–273. [Google Scholar] [CrossRef] [PubMed]
- Augustin, J.; Zemek, J.; Fassatiová, O.; Kuniak, L. Production of α-amylase by microscopic fungi. Folia Microbiol. 1981, 26, 142–146. [Google Scholar] [CrossRef] [PubMed]
- Gupta, A.K.; Nagpal, B.; Kaur, N.; Rathore, P.; Singh, R. Properties of invertase from Fusarium oxysporum. Proc. Indian Natn. Sci. Acad. 1989, 55, 505–512. [Google Scholar]
- Niture, S.K.; Kumar, A.R.; Parab, P.B.; Pant, A. Inactivation of polygalacturonase and pectate lyase produced by pH tolerant fungus Fusarium moniliforme NCIM 1276 in a liquid medium and in the host tissue. Microbiol. Res. 2008, 163, 51–62. [Google Scholar] [CrossRef]
- Sunitha, V.H.; Ramesha, A.; Savitha, J.; Srinivas, C. Amylase production by endophytic fungi Cylindrocephalum sp. isolated from medicinal plant Alpinia calcarata (Haw.) Roscoe. Braz. J. Microbiol. 2012, 43, 1213–1221. [Google Scholar] [CrossRef]
- Syrchin, S.O.; Kharkevych, O.S.; Pavlychenko, A.K.; Yurieva, O.M.; Nakonechna, L.T.; Kurchenko, I.M. Extracellular cellulolytic complexes production by microscopic fungi. Biotechnol. Acta 2015, 8, 78–85. [Google Scholar] [CrossRef]
- Oyedeji, O.; Iluyomade, A.; Egbewumi, I.; Odufuwa, A. Isolation and screening of xylanolytic fungi from soil of botanical garden: Xylanase production from Aspergillus flavus and Trichoderma viride. J. Microbiol. Res. 2018, 8, 9–18. [Google Scholar] [CrossRef]
- Gao, H.; Wang, Y.; Zhang, W.; Wang, W.; Mu, Z. Isolation, identification and application in lignin degradation of an ascomycete GHJ-Afr. J. Biotechnol. 2011, 10, 4166–4174. [Google Scholar] [CrossRef]
- Barapatre, A.; Jha, H. Degradation of alkali lignin by two ascomycetes and free radical scavenging activity of the products. Biocatal. Biotransform. 2017, 35, 269–286. [Google Scholar] [CrossRef]
- Rombouts, F.; Voragen, A.; Leeuwen, M.S.-V.; Geraeds, C.; Schols, H.; Pilnik, W. The arabinanases of Aspergillus niger—Purification and characterisation of two α-l-arabinofuranosidases and an endo-1,5-α-l-arabinanase. Carbohydr. Polym. 1988, 9, 25–47. [Google Scholar] [CrossRef]
- Luonteri, E.; Beldman, G.; Tenkanen, M. Substrate specificities of Aspergillus terreus α-arabinofuranosidases. Carbohydr. Polym. 1998, 37, 131–141. [Google Scholar] [CrossRef]
- De Ioannes, P.; Peirano, A.; Steiner, J.; Eyzaguirre, J. An α-L-arabinofuranosidase from Penicillium purpurogenum: Production, purification and properties. J. Biotechnol. 2000, 76, 253–258. [Google Scholar] [CrossRef]
- Budak, S.O.; Zhou, M.; Brouwer, C.; Wiebenga, A.; Benoit, I.; Di Falco, M.; Tsang, A.; De Vries, R.P. A genomic survey of proteases in Aspergilli. BMC Genom. 2014, 15, 1–15. [Google Scholar] [CrossRef]
- Chandrasekaran, S.; Kumaresan, S.S.P.; Manavalan, M. Production and optimization of protease by filamentous fungus isolated from paddy soil in Thiruvarur District Tamilnadu. J. App. Biol. Biotech. 2015, 3, 66–69. [Google Scholar] [CrossRef]
- Saxena, J.; Choudhary, N.; Gupta, P.; Sharma, M.M.; Singh, A. Isolation and characterization of neutral proteases producing soil fungus Cladosporium sp. PAB2014 Strain FGCC/BLS2: Process Optimization for Improved Enzyme Production. J. Sci. Ind. Res. India 2017, 76, 707–717. [Google Scholar]
- Liu, X.; Xie, J.; Fu, Y.; Jiang, D.; Chen, T.; Cheng, J. The Subtilisin-Like Protease Bcser2 Affects the Sclerotial Formation, Conidiation and Virulence of Botrytis cinerea. Int. J. Mol. Sci. 2020, 21, 603. [Google Scholar] [CrossRef]
- Brito, N.; Espino, J.J.; González, C. The Endo-β-1,4-Xylanase Xyn11A Is Required for Virulence in Botrytis cinerea. Mol. Plant-Microbe Interact. 2006, 19, 25–32. [Google Scholar] [CrossRef]
- Yu, C.; Li, T.; Shi, X.; Saleem, M.; Li, B.; Liang, W.; Wang, C. Deletion of Endo-β-1,4-Xylanase VmXyl1 Impacts the Virulence of Valsa mali in Apple Tree. Front. Plant Sci. 2018, 9, 663. [Google Scholar] [CrossRef]
- Flajšman, M.; Mandelc, S.; Radišek, S.; Stajner, N.; Jakše, J.; Kosmelj, K.; Javornik, B. Identification of Novel Virulence-Associated Proteins Secreted to Xylem by Verticillium nonalfalfae During Colonization of Hop Plants. Mol. Plant-Microbe Interac. 2016, 29, 362–373. [Google Scholar] [CrossRef]
- Di Pietro, A.; Huertas-González, M.D.; Gutierrez-Corona, J.F.; Martínez-Cadena, G.; Méglecz, E.; Roncero, M.I.G. Molecular Characterization of a Subtilase from the Vascular Wilt Fungus Fusarium oxysporum. Mol. Plant-Microbe Interac. 2001, 14, 653–662. [Google Scholar] [CrossRef] [PubMed]
- Plummer, K.M.; Clark, S.J.; Ellis, L.M.; Loganathan, A.; Al-Samarrai, T.H.; Rikkerink, E.H.; Sullivan, P.A.; Templeton, M.D.; Farley, P.C. Analysis of a Secreted Aspartic Peptidase Disruption Mutant of Glomerella cingulata. Eur. J. Plant Pathol. 2004, 110, 265–274. [Google Scholar] [CrossRef]
- Have, A.T.; Espino, J.J.; Dekkers, E.; Van Sluyter, S.C.; Brito, N.; Kay, J.; González, C.; Van Kan, J.A. The Botrytis cinerea aspartic proteinase family. Fungal Genet. Biol. 2010, 47, 53–65. [Google Scholar] [CrossRef] [PubMed]
- Apel, P.C.; Panaccione, D.G.; Holden, F.R.; Walton, J.D. Cloning and targeted gene disruption of XYL1, aβ-1,4-xylanase gene from the maize pathogen Cochliobolus carbonum. Mol. Plant Microbe Interact. 1993, 6, 467–473. [Google Scholar] [CrossRef]
- Wu, S.-C.; Kauffmann, S.; Darvill, A.G.; Albersheim, P. Purification, cloning and characterization of two xylanases from Magna-porthe grisea, the rice blast fungus. Mol. Plant Microbe Interact. 1995, 8, 506–514. [Google Scholar] [CrossRef]
- Apel-Birkhold, P.C.; Walton, J.D. Cloning, disruption, and expression of two endo-beta 1, 4-xylanase genes, XYL2 and XYL3, from Cochliobolus carbonum. Appl. Environ. Microbiol. 1996, 62, 4129–4135. [Google Scholar] [CrossRef]
- Wegener, S.; Ransom, R.F.; Walton, J.D. A unique eukaryotic β-xylosidase gene from the phytopathogenic fungus Cochliobolus carbonum. Microbiology 1999, 145, 1089–1095. [Google Scholar] [CrossRef][Green Version]
- Roncero, M.B.; Torres, A.L.; Colom, J.F.; Vidal, T. TCF bleaching of wheat straw pulp using ozone and xylanase. Part A: Paper quality assessment. Bioresour. Technol. 2003, 87, 305–314. [Google Scholar] [CrossRef]
- Gómez-Gómez, E.; Roncero, I.M.; Di Pietro, A.; Hera, C. Molecular characterization of a novel endo-β-1,4-xylanase gene from the vascular wilt fungus Fusarium oxysporum. Curr. Genet. 2001, 40, 268–275. [Google Scholar] [CrossRef]
- Gómez-Gómez, E.; Ruíz-Roldán, M.; Di Pietro, A.; Roncero, M.; Hera, C. Role in Pathogenesis of Two Endo-β-1,4-xylanase Genes from the Vascular Wilt Fungus Fusarium oxysporum. Fungal Genet. Biol. 2002, 35, 213–222. [Google Scholar] [CrossRef]
- Sella, L.; Gazzetti, K.; Faoro, F.; Odorizzi, S.; D’Ovidio, R.; Schäfer, W.; Favaron, F. A Fusarium graminearum xylanase expressed during wheat infection is a necrotizing factor but is not essential for virulence. Plant Physiol. Biochem. 2013, 64, 1–10. [Google Scholar] [CrossRef] [PubMed]
- Rogers, L.M.; Kim, Y.-K.; Guo, W.; González-Candelas, L.; Li, D.; Kolattukudy, P.E. Requirement for either a host- or pectin-induced pectate lyase for infection of Pisum sativum by Nectria hematococca. Proc. Natl. Acad. Sci. USA 2000, 97, 9813–9818. [Google Scholar] [CrossRef] [PubMed]
- Roncero, M.I.G.; Hera, C.; Ruiz-Rubio, M.; Maceira, F.I.G.; Madrid, M.P.; Caracuel, Z.; Calero, F.; Delgado-Jarana, J.; Roldán-Rodrıguez, R.; Martínez-Rocha, A.L.; et al. Fusarium as a model for studying virulence in soilborne plant pathogens. Physiol. Mol. Plant Pathol. 2003, 62, 87–98. [Google Scholar] [CrossRef]
- Jashni, M.K.; Dols, I.H.; Iida, Y.; Boeren, S.; Beenen, H.G.; Mehrabi, R.; de Wit, P.J. Synergistic action of a metalloprotease and a serine protease from Fusarium oxysporum f. sp. lycopersici cleaves chitin-binding tomato chitinases, reduces their antifungal activity, and enhances fungal virulence. Mol. Plant Microbe Interact. 2015, 28, 996–1008. [Google Scholar] [CrossRef]
- Paccanaro, M.C.; Sella, L.; Castiglioni, C.; Giacomello, F.; Martínez-Rocha, A.L.; D’Ovidio, R.; Favaron, F. Synergistic Effect of Different Plant Cell Wall—Degrading Enzymes Is Important for Virulence of Fusarium graminearum. Mol. Plant-Microbe Interact. 2017, 30, 886–895. [Google Scholar] [CrossRef]
- Grosch, R.; Schumann, K. Aggressiveness behaviour of Microdochium nivale Samuels & Hallett of forage grasses. Arch. Phytopathol. Plant Protect. 1993, 28, 139–146. [Google Scholar]
- Jaroszuk-Ściseł, J.; Kurek, E.; Słomka, A.; Janczarek, M.; Rodzik, B. Activities of cell wall degrading enzymes in autolyzing cultures of three Fusarium culmorum isolates: Growth-promoting, deleterious and pathogenic to rye (Secale cereale). Mycologia 2011, 103, 929–945. [Google Scholar] [CrossRef]

| Cluster | Strain No | Number of Roots | Number of Leaves | Root Length (cm) | Shoot Length (cm) | Root Weight (g) | Shoot Weight (g) | Plant Weight (g) |
| 1. Highly virulent | 1, 5, 6, 8, 9, 11, 12, 13, 14, 15, 21 | 7.0 (a) | 3.1 (a) | 4.4 (a) | 21.4 (a) | 0.4 (a) | 1.5 (a) | 1.9 (a) |
| 2. Moderately virulent | 3, 7, 10, 16 | 7.9 (a) | 3.6 (a) | 7.8 (b) | 32.5 (b) | 1.2 (b) | 4.0 (b) | 5.2 (b) |
| 3. Low virulent | 19, 20 | 7.9 (a) | 3.5 (a) | 8.8 (bc) | 34.3 (bc) | 1.5 (c) | 4.6 (bc) | 6.1 (bc) |
| 4. Avirulent | 2, 4, 17, 18 | 7.6 (a) | 3.5 (a) | 10.4 (cd) | 35.7 (bc) | 1.7 (d) | 5.0 (cd) | 6.7 (c) |
| Control plants | 6.8 (a) | 4.2 (a) | 12.3 (d) | 37.8 (c) | 2.3 (e) | 5.8 (d) | 8.1 (d) | |
| Cluster | Strain No | % of Plants with Brownish Roots | % of Plants with Stem Necrosis | % of Plants with Leaf Necrosis | ||||
| 1. Highly virulent | 1, 5, 6, 8, 9, 11, 12, 13, 14, 15, 21 (c) | 99.4 | 98.8 (c) | 89.3 (b) | ||||
| 2. Moderately virulent | 3, 7, 10, 16 (b) | 72.8 | 32.8 (b) | 20.0 (a) | ||||
| 3. Low virulent | 19, 20 (a) | 19.5 | 10.0 (a) | 10.0 (a) | ||||
| 4. Avirulent | 2, 4, 17, 18 (a) | 8.8 | 0 (a) | 0 (a) | ||||
| Control plants | (a) | 0 | 0 (a) | 0 (a) | ||||
Publisher’s Note: MDPI stays neutral with regard to jurisdictional claims in published maps and institutional affiliations. |
© 2020 by the authors. Licensee MDPI, Basel, Switzerland. This article is an open access article distributed under the terms and conditions of the Creative Commons Attribution (CC BY) license (http://creativecommons.org/licenses/by/4.0/).
Share and Cite
Gorshkov, V.; Osipova, E.; Ponomareva, M.; Ponomarev, S.; Gogoleva, N.; Petrova, O.; Gogoleva, O.; Meshcherov, A.; Balkin, A.; Vetchinkina, E.; et al. Rye Snow Mold-Associated Microdochium nivale Strains Inhabiting a Common Area: Variability in Genetics, Morphotype, Extracellular Enzymatic Activities, and Virulence. J. Fungi 2020, 6, 335. https://doi.org/10.3390/jof6040335
Gorshkov V, Osipova E, Ponomareva M, Ponomarev S, Gogoleva N, Petrova O, Gogoleva O, Meshcherov A, Balkin A, Vetchinkina E, et al. Rye Snow Mold-Associated Microdochium nivale Strains Inhabiting a Common Area: Variability in Genetics, Morphotype, Extracellular Enzymatic Activities, and Virulence. Journal of Fungi. 2020; 6(4):335. https://doi.org/10.3390/jof6040335
Chicago/Turabian StyleGorshkov, Vladimir, Elena Osipova, Mira Ponomareva, Sergey Ponomarev, Natalia Gogoleva, Olga Petrova, Olga Gogoleva, Azat Meshcherov, Alexander Balkin, Elena Vetchinkina, and et al. 2020. "Rye Snow Mold-Associated Microdochium nivale Strains Inhabiting a Common Area: Variability in Genetics, Morphotype, Extracellular Enzymatic Activities, and Virulence" Journal of Fungi 6, no. 4: 335. https://doi.org/10.3390/jof6040335
APA StyleGorshkov, V., Osipova, E., Ponomareva, M., Ponomarev, S., Gogoleva, N., Petrova, O., Gogoleva, O., Meshcherov, A., Balkin, A., Vetchinkina, E., Potapov, K., Gogolev, Y., & Korzun, V. (2020). Rye Snow Mold-Associated Microdochium nivale Strains Inhabiting a Common Area: Variability in Genetics, Morphotype, Extracellular Enzymatic Activities, and Virulence. Journal of Fungi, 6(4), 335. https://doi.org/10.3390/jof6040335






